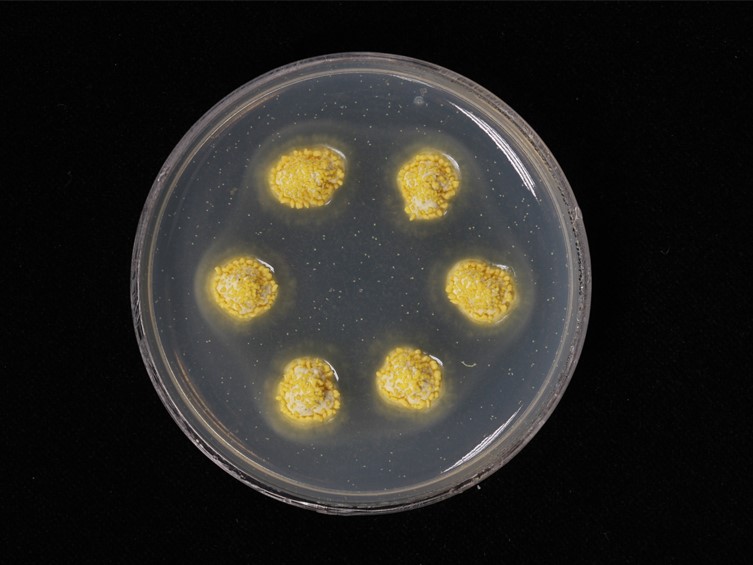

Holotype:
THAILAND, Chantaburi Province, Khao Soi Dao Wildlife Sanctuary, 8 Jun. 2005, N. Boonyuen, J. Luangsa-ard, S. Mongkolsamrit, P. Srikitikulchai, K. Tasanathai, B. Tongnuch, W. Tongsridam, holotype BBH 13011, ex-type living culture BCC 19360.
Habitat:
Underside of dicotyledonous leaves.
Host:
Scale insect nymph (Hemiptera).
Description:
 Stromata discoid to stud-shaped, up to 3 mm diam, up to 2.5 mm high, upper surface rounded (occasionally flat) or umbilicate in anamorph, pale yellow. Hypothallus fibrillose, hyaline to pale yellow.
Stromata discoid to stud-shaped, up to 3 mm diam, up to 2.5 mm high, upper surface rounded (occasionally flat) or umbilicate in anamorph, pale yellow. Hypothallus fibrillose, hyaline to pale yellow.  Perithecia immersed, ostiole slightly projecting, translucent, scattered, flask shaped, 300-400 × 150-200 μm.
Perithecia immersed, ostiole slightly projecting, translucent, scattered, flask shaped, 300-400 × 150-200 μm.  Asci 8-spored, up to 170 × 7.5-8.0 μm.
Asci 8-spored, up to 170 × 7.5-8.0 μm.  Ascospores whole, non-fragmenting, 75-120 × 2 μm, blunt at one end tapering to tail.
Ascospores whole, non-fragmenting, 75-120 × 2 μm, blunt at one end tapering to tail.  Conidiomata 300-400 × 200-350 μm.
Conidiomata 300-400 × 200-350 μm.  Phialides up to 25 μm, 1.5-2.0 μm.
Phialides up to 25 μm, 1.5-2.0 μm.  Paraphyses linear, filiform, flexuous, up to 300 μm long, up to 2.0 μm wide.
Paraphyses linear, filiform, flexuous, up to 300 μm long, up to 2.0 μm wide.  Conidia 10-12.5 × 2.0-2.5 μm.
Conidia 10-12.5 × 2.0-2.5 μm.
Culture characteristics:
Colonies on PDA slow-growing, attaining a diam of 5–7 mm in 4 wk, yellow crystals scattered in PDA with old cultures. Stromatic colonies pale yellow to yellowish white, forming moderately compact stromata, surrounded by slight, whitish mycelial margin. Conidial masses, pale yellow to yellow, appeared as abundant slime masses from pycnidia.
Colonies on PDA slow-growing, attaining a diam of 5–7 mm in 4 wk, yellow crystals scattered in PDA with old cultures. Stromatic colonies pale yellow to yellowish white, forming moderately compact stromata, surrounded by slight, whitish mycelial margin. Conidial masses, pale yellow to yellow, appeared as abundant slime masses from pycnidia.
Reference:
Mongkolsamrit S, Luangsa-ard JJ, Spatafora JW, et al. (2009). A combined ITS rDNA and beta-tubulin phylogeny of Thai species of Hypocrella with non-fragmenting ascospores. Mycological Research 113: 684–699.
DOI: https://doi.org/10.1016/j.mycres.2009.02.004Species |
Strain |
Compound |
Pubchem CID |
Biological activity |
Reference |
|---|
|
Strain |
ITS | β-tubulin |
|---|---|---|
| BCC 18563 | EU409586 | EU409570 |
| BCC 19360 | EU409592 | EU409578 |